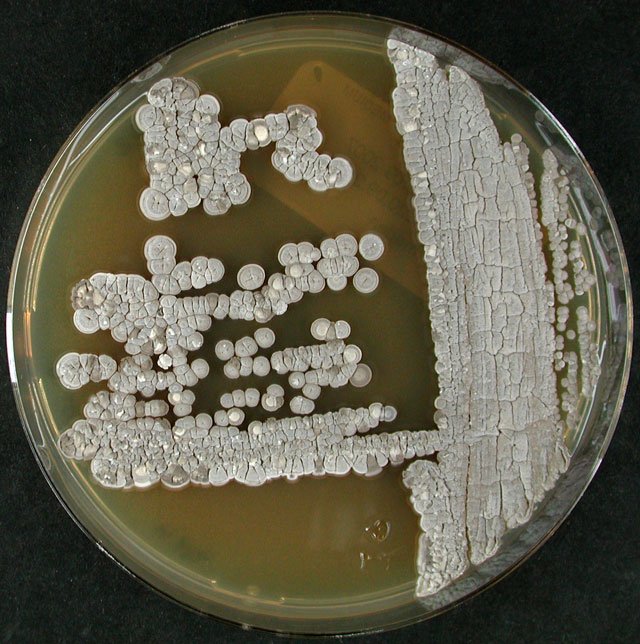

Other than mRNA and DNA vector agents themselves, there has been no other medication in the last three years that has been as politically controversial as ivermectin.
Ivermectins’ impacts in controlling tropical diseases which blighted the lives of billions of the poor throughout the tropics, is why its discoverers were awarded the Nobel Prize in Medicine in 2015 and the reason for its inclusion on the WHO’s “List of Essential Medicines.”
Ivermectin is not only an effective anti-parasitic but is generally well tolerated, has a broad-spectrum effect, is safe, easily administered, and is cheap.
With regards to having anti-viral properties, ivermectin has been shown in in vitro studies to have properties against an increasing number of RNA viruses, including influenza, Zika, HIV, Dengue, and SARS-CoV-2.
portlandpress.com
portlandpress.com
It has also shown promise as an antibacterial and anticancer agent and may even help with motor neurone disease.
nature.com
nature.com
Ivermectin gained much interest as a promising treatment option against SARS-CoV-2 in 2020 when researchers published their study results showing that it inhibited the replication of SARS-CoV-2 in cell culture.
ncbi.nlm.nih.gov
ncbi.nlm.nih.gov
Other studies since then have shown that ivermectin can bind to the host receptor-binding region of the SARS-CoV-2 spike protein.
ncbi.nlm.nih.gov
ncbi.nlm.nih.gov
In fact, ivermectin has been identified as having the highest or among the highest binding affinities to spike protein S1 binding domains of SARS-CoV-2 among hundreds of molecules collectively examined.
#S7" target="_blank" rel="noopener" onclick="event.stopPropagation()">europepmc.org
#S7" target="_blank" rel="noopener" onclick="event.stopPropagation()">europepmc.org
Ivermectin has also been shown to bind to or interfere with multiple essential proteins required by the virus in order to replicate, inhibiting viral replication.
ncbi.nlm.nih.gov
ncbi.nlm.nih.gov
Lab studies do not always reflect human trials.
And this is where the controversy begins.
Firstly, it is undeniable that various trials have found that the use of ivermectin in those with COVID-19 helped with recovery.
And this is where the controversy begins.
Firstly, it is undeniable that various trials have found that the use of ivermectin in those with COVID-19 helped with recovery.
In one study of four hundred patients, the use of 0.4 mg/kg ivermectin was associated with a statistically significant lower rate of progression of COVID-19.
ncbi.nlm.nih.gov
ncbi.nlm.nih.gov
In another study of 280 hospitalised patients, a statistically significant lower mortality rate was found among ivermectin-treated patients.
ncbi.nlm.nih.gov
ncbi.nlm.nih.gov
And a meta-analysis of 15 trials found that ivermectin reduced the risk of death in COVID-19 patients compared with no ivermectin use.
ncbi.nlm.nih.gov
ncbi.nlm.nih.gov
Other than trial data, real-life evidence seems to support ivermectin use too.
In Peru, one of the worst-hit nations in terms of COVID-19 disease and death, the government approved the use of ivermectin by decree on May 8, 2020.
In Peru, one of the worst-hit nations in terms of COVID-19 disease and death, the government approved the use of ivermectin by decree on May 8, 2020.
After its introduction, a decrease in total case incidences and total deaths/population due to COVID-19 was noted.
This was also seen similarly in Paraguay.
This was also seen similarly in Paraguay.
However, though it has been noted in various studies that ivermectin hastens recovery and helps avoid ICU admission and death in hospitalised patients, this fact has not been shared by everyone.
Cochrane is a highly prestigious group that conducts systematic reviews of health-care interventions and diagnostic tests. In their review of 11 trials with a total of 3409 participants, they note,
“Based on the very low‐certainty evidence...
“Based on the very low‐certainty evidence...
... for inpatients, we are still uncertain whether ivermectin prevents death or clinical worsening or increases serious adverse events, while there is low‐certainty evidence that it has no beneficial effect regarding clinical improvement, viral clearance and adverse events.”
The differences in study outcomes may be due to differences in study design, biases, and differences in drug dosage and when it was used.
The FDA, referring to ivermectin, also tweeted
“You are not a horse. You are not a cow. Seriously, y'all. Stop it.
“You are not a horse. You are not a cow. Seriously, y'all. Stop it.
Understanding the ties between the government, pharmaceutical companies, and the mainstream media, it may not be too outlandish to assume that the heavy vilification of ivermectin, a safe, cheap, and possibly anti-COVID-19 drug, was actually a reflection of its effectiveness...
...and thus its position as a direct competitor to the thing they wanted to flog.
It is all the more worrying when these entities have already shown a track record of lying to the public. Only recently has a Pfizer executive admitted that the company did not test whether its COVID-19 jabs stopped transmission of the virus before its launch.
And yet ivermectin has shown repeatedly to prevent transmission and development of COVID-19 disease in those exposed to infected patients.
ncbi.nlm.nih.gov
ncbi.nlm.nih.gov
Dosage:
It is not officially advised to use ivermectin to treat COVID-19 and/or long COVID.
It is not officially advised to use ivermectin to treat COVID-19 and/or long COVID.
The Front Line COVID-19 Critical Care Alliance (FLCCC) recommends 0.2mg/kg per dose of ivermectin as a prophylaxis for high-risk individuals, noting to use “one dose today, 2nd dose in 48 hours, then one dose every 2 weeks.”
Ivermectin is also recommended at a dose of 0.2 mg/kg per dose as part of the Early Outpatient Treatment Protocol by the FLCCC. They note “one dose daily for minimum of 2 days, continue daily until recovered (max 5 days).”
Loading suggestions...